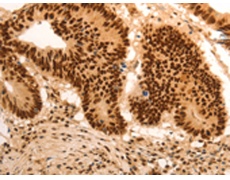
一抗

|
Background: |
Atypical E2F transcription factor that participates to various processes such as angiogenesis, polyploidization of specialized cells and DNA damage response. It plays a key role in polyploidization of cells in placenta and liver by regulating the endocycle, probably by repressing genes promoting cytokinesis and antagonizing action of classical E2F proteins (E2F1, E2F2 and/or E2F3). |
|
Applications: |
ELISA, IHC |
|
Name of antibody: |
E2F7 |
|
Immunogen: |
Synthetic peptide of human E2F7 |
|
Full name: |
E2F transcription factor 7 |
|
Synonyms: |
no |
|
SwissProt: |
Q96AV8 |
|
IHC positive control: |
Human colon cancer and human gastric cancer |
|
IHC Recommend dilution: |
50-200 |

 購(gòu)物車
購(gòu)物車 幫助
幫助
 021-54845833/15800441009
021-54845833/15800441009